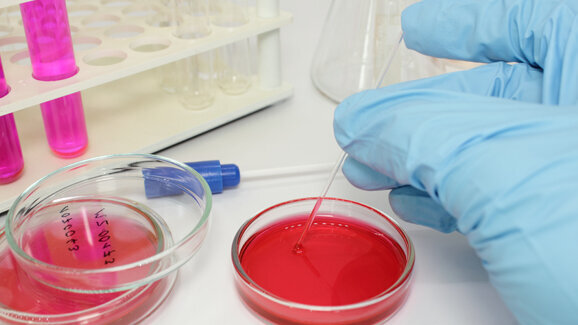
Forscher finden Ursache für Biofilm-Entstehung

NEWCASTLE - Biofilme entstehen, wenn sich Bakterienkolonien unter einer resistenten Schleimschicht gegen äußere Einflüsse schützen. Was aber die Kolonien veranlasst, einen Biofilm zu bilden, haben Forscher der Newcastle University genauer untersucht. Dabei beobachteten sie die Interaktion des Proteins SinR mit anderen Proteinen während es an die DNA gebunden ist und auch, während es das nicht ist.
Biofilme sind zähe Schleimstrukturen, unter denen Bakterienkolonien sich gegen ihre Feinde schützen. Sie können Zahnbelag und diverse Entzündungen verursachen, sowie an Implantaten zu lebensbedrohlichen Infektionen führen. Die Forscher untersuchten die Biofilmbildung des Heubazillus (Bacillus subtilis), um die Ursache für dessen Entstehungsmechanismus zu ergründen.
Das Protein SinR ist der Hauptregulator für die Bildung von Biofilmen. Dieses Protein interagiert mit drei anderen Proteinen. Je nach Einfluss dieser ist es entweder an die DNA gebunden oder nicht. Richard Lewis, Professor am Institut für Zelluläre und Molekulare Biowissenschaft, vergleicht SinR mit einem simplen Kippschalter. Im Falle der Bindung von SinR an die DNA sind die anderen Proteine, die für die Bildung eines Biofilms notwendig sind, inaktiv. Die Bakterien können sich frei bewegen und bilden keine zusammenhängende Struktur. Wenn SinR aktiv wird, der Schalter also auf „an“ umgelegt wird, dann ist es von der DNA losgelöst und interagiert mit den anderen Proteinen. In diesem Fall bilden sie einen Biofilm. Die Eigenschaft von SinR sich an die DNA zu binden ist die Grundlage, dass andere Proteine daran gehindert werden, einen molekularen „Klebstoff“ zu bilden, der den Biofilm zusammenhält.
Aus der Erkenntniss, wie die Proteine aufeinander wirken und mit der DNA reagieren, können die Forscher die Grundlage zur Bildung neuer Moleküle gewinnen. Diese ermöglichen dann eventuell, in die Wechselwirkungen zwischen den Proteinen einzugreifen und somit die Bildung von Biofilmen zu verhindern.
BERLIN – Manche Kinder werden mit einer Gaumenspalte geboren, und in einigen Fällen ist das Gesicht asymmetrisch und ein Ohr fehlgebildet. Ein ...
Rochester – Manche Babys knabbern mit sechs Monaten schon sichtbar, andere lassen sich Zeit mit dem Zahnen bis zum ersten Geburtstag. Wann das erste ...
NEW YORK, USA – 16 Jahre nach den Terroranschlägen beschäftigt sich ein Forscherteam in einer Pilotstudie mit den langfristigen Auswirkungen von ...
DRESDEN - Ein aktuelles Forschungsergebnis birgt neue Therapieansätze für die Behandlung von Parodontitis: Am Universitätsklinikum Carl ...
NEW YORK/USA – Dass eine ungesunde Ernährung, mangelnde Mundhygiene, Rauchen oder Diabetes eine Parodontitis begünstigen, ist bereits ...
INNSBRUCK - Einer interdisziplinären Arbeitsgruppe unter Leitung der Innsbrucker Humangenetik an der Medizinischen Universität Innsbruck gelang ...
MÜNCHEN - Welcher Mechanismus bei dem anhaltenden, bitteren Nachgeschmack von Stevia im Spiel ist und wie er überwunden werden könnte, haben ...
PORTUGAL – Bestimmte Merkmale, wie verlängerter Zahnschmelz des ersten Oberkiefermolaren, bestimmtes Überstehen der oberen Frontzähne ...
PORTUGAL – Bestimmte Merkmale, wie verlängerter Zahnschmelz des ersten Oberkiefermolaren, bestimmtes Überstehen der oberen Frontzähne ...
ANN ARBOR - Amerikanische Forscher haben in einer Studie untersucht, welche genetischen Faktoren eine leichtere Anfälligkeit für Parodontitis ...
Live-Webinar
Di. 23. Juni 2026
2:00 Uhr (CET) Vienna
Live-Webinar
Di. 23. Juni 2026
19:00 Uhr (CET) Vienna
Live-Webinar
Di. 23. Juni 2026
21:00 Uhr (CET) Vienna
Live-Webinar
Mi. 24. Juni 2026
14:00 Uhr (CET) Vienna
Live-Webinar
Mi. 24. Juni 2026
17:00 Uhr (CET) Vienna
Live-Webinar
Mi. 24. Juni 2026
18:30 Uhr (CET) Vienna
Dr. med. dent. Britta Hahn
Live-Webinar
Do. 25. Juni 2026
20:00 Uhr (CET) Vienna
Dr. Hatem Algraffee, Cat Edney



 Österreich / Österreich
Österreich / Österreich
 Bosnien und Herzegowina / Босна и Херцеговина
Bosnien und Herzegowina / Босна и Херцеговина
 Bulgarien / България
Bulgarien / България
 Kroatien / Hrvatska
Kroatien / Hrvatska
 Tschechien & Slowakei / Česká republika & Slovensko
Tschechien & Slowakei / Česká republika & Slovensko
 Frankreich / France
Frankreich / France
 Deutschland / Deutschland
Deutschland / Deutschland
 Griechenland / ΕΛΛΑΔΑ
Griechenland / ΕΛΛΑΔΑ
 Ungarn / Hungary
Ungarn / Hungary
 Italien / Italia
Italien / Italia
 Niederlande / Nederland
Niederlande / Nederland
 Nordic / Nordic
Nordic / Nordic
 Polen / Polska
Polen / Polska
 Portugal / Portugal
Portugal / Portugal
 Rumänien & Moldawien / România & Moldova
Rumänien & Moldawien / România & Moldova
 Slowenien / Slovenija
Slowenien / Slovenija
 Serbien & Montenegro / Србија и Црна Гора
Serbien & Montenegro / Србија и Црна Гора
 Spanien / España
Spanien / España
 Schweiz / Schweiz
Schweiz / Schweiz
 Türkei / Türkiye
Türkei / Türkiye
 Großbritannien und Irland / UK & Ireland
Großbritannien und Irland / UK & Ireland
 International / International
International / International
 Brasilien / Brasil
Brasilien / Brasil
 Kanada / Canada
Kanada / Canada
 Lateinamerika / Latinoamérica
Lateinamerika / Latinoamérica
 USA / USA
USA / USA
 China / 中国
China / 中国
 Indien / भारत गणराज्य
Indien / भारत गणराज्य
 Pakistan / Pākistān
Pakistan / Pākistān
 Vietnam / Việt Nam
Vietnam / Việt Nam
 ASEAN / ASEAN
ASEAN / ASEAN
 Israel / מְדִינַת יִשְׂרָאֵל
Israel / מְדִינַת יִשְׂרָאֵל
 Algerien, Marokko und Tunesien / الجزائر والمغرب وتونس
Algerien, Marokko und Tunesien / الجزائر والمغرب وتونس
 Naher Osten / Middle East
Naher Osten / Middle East

To post a reply please login or register